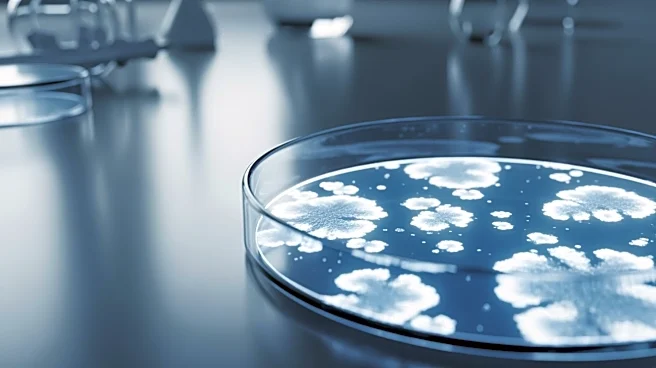

What's Happening?
Mundipharma has announced positive topline results from its Phase III ReSPECT trial, which evaluated the efficacy of REZZAYO (rezafungin) for preventing invasive fungal diseases in patients undergoing allogeneic haematopoietic stem cell transplantation.
The trial met its primary endpoint, demonstrating non-inferiority to standard antimicrobial regimens in fungal-free survival at Day 90. Rezafungin showed a favorable safety profile and was well tolerated, with fewer toxicity-related discontinuations and drug-drug interactions compared to standard treatments.
Why It's Important?
The successful trial results for rezafungin represent a significant advancement in the prophylactic treatment of invasive fungal diseases, particularly for immunocompromised patients. This development could lead to improved patient outcomes and reduced healthcare costs associated with fungal infections. The findings also highlight the potential for rezafungin to become a new standard of care, offering a more effective and safer alternative to existing treatments. This could have a substantial impact on the pharmaceutical industry and healthcare providers, as they seek to address the unmet needs of vulnerable patient populations.
What's Next?
Following the positive trial results, Mundipharma plans to submit a supplemental New Drug Application to the U.S. FDA and a similar application to the European Medicines Agency later this year. If approved, rezafungin could be introduced to the market, providing a new option for healthcare providers in managing invasive fungal diseases. The company will likely focus on further clinical research and potential expansion of rezafungin's indications, as well as strategic partnerships to enhance its market reach.